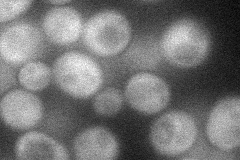
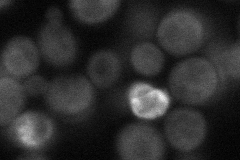
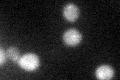
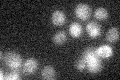

View description
Protein that interacts with silencing proteins at the telomere, involved in transcriptional silencing; implicated in the mitotic exit network through regulation of Cdc14p localization; paralog of Zds1p
Localization:
Intensity:
Fold change:
Significance:
-
C’ GFP library in SD

cytosol20.37 -
N' NOP1pr-GFP in SD
cytosol38.3408 -
N' TEF2pr-mCherry in SD
cytosol32.448 -
N' NATIVEpr-GFP in SD

missing0 -
N' TEF2pr-VC and Cyto-VN in SD

cytosol37.8913 -
C’ GFP library in SD+DTT
cytosol23.511.15No -
C’ GFP library in SD+H2O2

cytosol22.721.11No -
C’ GFP library in Starvation Media
cytosol18.350.9No -
C’ GFP library on the background of Pup2-DaMP

cytosol -
C’ GFP library on the background of CCT mutant

cytosol20.97511.02926No
